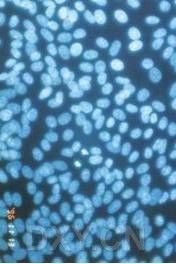

污染是細(xì)胞培養(yǎng)的大敵。預(yù)防和避免污染是細(xì)胞培養(yǎng)成功的關(guān)鍵之一。一開始就要十分重視,防止污染,否則會前功盡棄,不僅浪費(fèi)時間,而且浪費(fèi)人力、物力,甚至造成無法彌補(bǔ)的損失。
(一)污染的類型
細(xì)胞培養(yǎng)過程中的污染不僅僅指微生物,而且還包括所有混入培養(yǎng)環(huán)境中的、對細(xì)胞生存有害或造成細(xì)胞不純的物質(zhì),包括生物和化學(xué)物質(zhì)。
1、細(xì)菌污染
細(xì)菌污染是實驗室細(xì)胞培養(yǎng)中常見的污染,即使在細(xì)胞培養(yǎng)液中加入了抗菌素,也可能因為操作不慎而引起污染。最常見的有革蘭氏陽性菌,如枯草桿菌以及大腸桿菌、假單胞菌等革蘭氏陰性菌,其中又以白色葡萄球菌較常見。
培養(yǎng)細(xì)胞受細(xì)菌污染后,會出現(xiàn)培養(yǎng)液變混濁,pH改變。污染后細(xì)胞發(fā)生病理改變,胞內(nèi)顆粒增多、增粗,最后變圓脫落死亡。
2、真菌污染
真菌污染是細(xì)胞培養(yǎng)過程中最常見的一種,最常見的真菌有煙曲霉、黑曲菌、孔子霉、毛霉菌、白色念珠菌和酵母菌。
培養(yǎng)細(xì)胞受真菌污染后,可見培養(yǎng)液中漂浮著白色或淺黃色的小點(diǎn),有的散在生長,培養(yǎng)液一般不發(fā)生混濁;倒置顯微鏡下可見絲狀、管狀或樹枝狀的菌絲縱橫交錯在細(xì)胞之間或培養(yǎng)基中,有的呈鏈狀排列。
真菌污染后,細(xì)胞生長變慢,但最后由于營養(yǎng)耗盡及毒性作用而使細(xì)胞脫落死亡。

絲狀菌污染
3、支原體污染
支原體是介于細(xì)菌與病毒之間能獨(dú)立生活的最小微生物,最小直徑0.2μm,一般過濾除菌無法去除它,光鏡下難以看清它的形態(tài)結(jié)構(gòu)。開始不易發(fā)現(xiàn),能在偏堿條件下生存,對青霉素有抗藥性。多吸附于細(xì)胞表面或散在于細(xì)胞之間。
培養(yǎng)細(xì)胞受支原體污染后,部分敏感細(xì)胞可見細(xì)胞生長增殖變慢,部分細(xì)胞變圓,從瓶壁脫落。但多數(shù)細(xì)胞污染后無明顯變化,或略有變化,若不及時處理,還會產(chǎn)生交叉污染。
陽性 陰性
4、病毒污染
組織細(xì)胞培養(yǎng)過程中,如果沒有除去潛在的病毒,就會產(chǎn)生病毒污染。目前,從原代猴腎細(xì)胞的培養(yǎng)中已發(fā)現(xiàn)不少于20種血清性病毒。
盡管病毒污染的細(xì)胞不影響原代培養(yǎng),但生產(chǎn)疫苗是不安全的。因此,潛在病毒是細(xì)胞大量生產(chǎn)和疫苗、干擾素等生物制品制作中的難題。
5、非同種細(xì)胞污染
由于細(xì)胞培養(yǎng)操作時各細(xì)胞株所需的器材和溶液沒有嚴(yán)格分開,往往會使一種細(xì)胞被另一種細(xì)胞污染。目前,世界上已有幾十種細(xì)胞都被HeLa細(xì)胞所污染,致使許多實驗宣告無效。
非細(xì)胞培養(yǎng)物所造成的化學(xué)成分的污染也偶有發(fā)生,大多是由于細(xì)胞培養(yǎng)所需物品清洗消毒不徹底而帶入一些有毒化學(xué)物質(zhì)所致。
(二)污染的鑒別
1、細(xì)菌、真菌污染的檢測
(1)肉眼觀察
細(xì)菌、真菌污染常在傳代、換液、加樣等開放性操作之后發(fā)生,而且增生迅速,若有污染,在48小時內(nèi)可明顯觀察到,例如培養(yǎng)液變混濁,或略加振蕩有很多漂浮物漂起。
(2)接種觀察
采用普通肉湯接種或用未加雙抗藥物的培養(yǎng)液接種,也可發(fā)現(xiàn)是否有污染。
(3)鏡下觀察
在倒置顯微鏡的高倍鏡下可見培養(yǎng)液中有大量圓球狀顆粒漂浮,即為細(xì)菌污染。
若細(xì)胞之間有絲狀、管狀、樹枝狀或卵形的物質(zhì)常為真菌污染。
2、支原體污染的檢測
(1)相差顯微鏡觀察
直接取少許培養(yǎng)液滴在載物片上,再蓋上蓋片觀察,支原體在鏡下呈暗色微小顆粒,多位于細(xì)胞與細(xì)胞之間,有時可見類似于布朗運(yùn)動的表現(xiàn)。應(yīng)注意與細(xì)胞破碎溢出的內(nèi)容物如線粒體等相區(qū)別。
(2)熒光染色法觀察
用熒光染料Hoechst33258,此染料能與DNA特異地結(jié)合,可使支原體內(nèi)的DNA著色,熒光顯微鏡下支原體呈綠色小點(diǎn),散在于細(xì)胞周圍或附于細(xì)胞表面。
(3)電鏡檢測
若條件許可,可用掃描電鏡或透射電鏡觀察。一般在細(xì)胞培養(yǎng)48~72小時,細(xì)胞接近匯合前,用胰酶消化細(xì)胞制成細(xì)胞懸液后進(jìn)行固定、包埋、切片后才能進(jìn)行觀察。

支原體掃描電鏡圖片
(4)培養(yǎng)檢測
將細(xì)胞懸液5mL加入45mL支原體肉湯培養(yǎng)基,培養(yǎng)14天后觀察肉湯培養(yǎng)有無霧狀沉淀,然后取0.5ml加入已冷卻到50℃的培養(yǎng)基中,再用瓊脂培養(yǎng)基做分離培養(yǎng),37℃培養(yǎng)3天觀察有無“荷包蛋”菌落出現(xiàn)。
3 、病毒的檢測
1) 應(yīng)用電鏡技術(shù)快速診斷動物病毒病

冠狀病毒電鏡圖
2) 逆轉(zhuǎn)錄_聚合酶鏈反應(yīng)RT_PCR檢測病毒
(三)污染的清除
培養(yǎng)細(xì)胞一經(jīng)污染,多數(shù)較難處理。如果污染細(xì)胞價值不大,宜棄之;在尋找原因后徹底消毒操作室,復(fù)蘇或重新購置細(xì)胞,再培養(yǎng)。
若污染細(xì)胞價值較大,又難于重新得到,可采取以下辦法清除。
一、細(xì)菌和真菌的清除
1、使用抗生素
抗生素對殺滅細(xì)菌較有效。聯(lián)合用藥比單獨(dú)用藥效果好。預(yù)防用藥比污染后再用藥效果好。預(yù)防用藥一般用雙抗生素,污染后清除用藥需采用大于常用量5~10倍的沖洗法,于加藥后作用24~48小時,再換常規(guī)培養(yǎng)液。此法在污染早期有效。
二、支原體的清除
1、用MRA處理
用MRA(Mycoplasma Removal Agent)處理細(xì)胞,每4天換一次液,連續(xù)處理15天以確保細(xì)胞純潔健康,效果好.
2、用清洗純化法清除支原體污染的方法
細(xì)胞營養(yǎng)馴化→優(yōu)質(zhì)細(xì)胞群的篩選→細(xì)胞清洗→反復(fù)離心洗滌
其原理是利用離心力、細(xì)胞、微生物質(zhì)量和懸液的浮力差達(dá)到清除支原體的目的。由于支原體個體小且除發(fā)酵支原體外多為細(xì)胞外寄生,所以通過反復(fù)洗滌細(xì)胞和低速離心換液使其中潛在的支原體數(shù)量降低至極限。
如結(jié)合敏感抗生素的抑殺作用,可達(dá)到更好的效果。
3、藥物輔助加溫處理
先用藥物處理后,再將污染的組織培養(yǎng)物放在41℃培養(yǎng)18小時,可殺死支原體,但對細(xì)胞有不良影響。
4、使用支原體特異性血清
用5%的兔支原體免疫血清可去除支原體污染,因特異抗體可抑制支原體生長,故經(jīng)抗血清處理后11天即轉(zhuǎn)為陰性,并且5個月后仍為陰性。但此法比較麻煩,不如用抗生素方便、經(jīng)濟(jì)。
(四)、污染的預(yù)防
預(yù)防是防止細(xì)胞培養(yǎng)過程中發(fā)生污染的最好辦法。只有預(yù)防工作做在前,才能將發(fā)生污染的可能性降到最小程度。
一般預(yù)防可從以下幾方面著手:
1、添加抗生素
2、從物品、用品消毒滅菌著手
細(xì)胞培養(yǎng)所用物品清洗、消毒要徹底,各種溶液滅菌除菌要仔細(xì),并在無菌試驗陰性后才能使用。
操作室及剩余的無菌器材要定期清潔消毒滅菌。
3、從操作者做起
(1)進(jìn)無菌室前要用肥皂洗手,按規(guī)定穿隔離衣。工作開始要先用75%酒精棉球擦手、擦瓶口和燒灼瓶口。
(2)操作者動作要輕,必須在火焰周圍無菌區(qū)內(nèi)打開瓶口,并將瓶口轉(zhuǎn)動燒灼。操作時盡量不要談話,若打噴嚏或咳嗽應(yīng)轉(zhuǎn)向背面。
(3)操作時要常更換吸管,一旦發(fā)現(xiàn)吸管口接觸了手和其他污染物品應(yīng)棄去。實驗完畢用消毒水浸泡的紗布擦臺面。
4、防止細(xì)胞交叉污染
在進(jìn)行多種細(xì)胞培養(yǎng)操作時,所用器具要嚴(yán)格區(qū)分。
在進(jìn)行換液或傳代操作時,注射器和滴管不要觸及細(xì)胞培養(yǎng)瓶瓶口,以免把細(xì)胞帶到培養(yǎng)液中污染其他細(xì)胞。
細(xì)胞一旦購置或從別處引入,均應(yīng)及早留種凍存,一旦發(fā)生污染可重新復(fù)蘇培養(yǎng)。
5、無菌室的徹底消毒
1) 0.1%新潔爾滅全面徹底擦洗無菌室;
2)甲醛熏蒸法:甲醛是一種廣譜滅菌劑菌,其水溶液和氣休對各種細(xì)菌、芽孢及真菌等微生物均有殺滅作用。